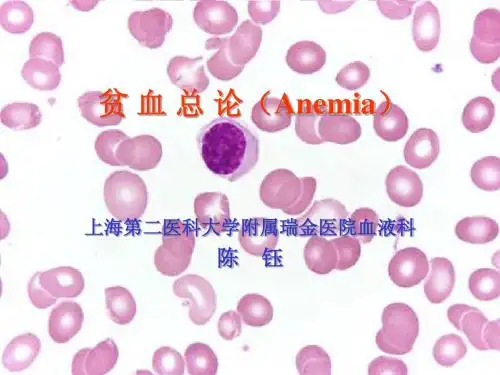

外铁(++)
外铁(—)
缺铁性贫血诊断
缺铁(ID,潜在缺铁期):骨髓外铁缺如,血清 铁蛋白<12ug/L,Hb及血清铁正常
缺铁性红细胞生成(IDE):血清铁蛋白及转铁 蛋白饱和度↓,FEP/Hb>4.5ug/gHb,Hb正常
缺铁性贫血(IDA):小细胞低色素贫血,MCV < 80fl、MCH<27pg、MCHC <32%,各项指标 均↓,Hb <120g/L(女<110g/L)
1.疲乏无力, 困倦──最早症状 2.皮肤粘膜苍白──最早最突出体征 3.各器官系统表现: 呼吸循环(心悸、气促),
神经系统 (头晕眼花、嗜睡、神志不清), 消化系统 (纳差、腹胀), 泌尿生殖系统 (蛋白尿、少尿、无尿), 内分泌系统
四、贫血的诊断
诊断三步法:
确定是否贫血 确定哪种类型贫血 确定贫血的原因
(Plummer-Vinson综合征:吞咽梗阻感) 末梢神经炎;烦躁; 智能障碍;异食癖; 等
四、实验室检查(laboratory features)
血象: 小细胞低色素性----RBC大小不等, 中心淡染区扩大。
BM象: RBC增生活跃, 铁染色细胞内铁↓和 外铁(-)
铁代谢:血清铁↓ 铁蛋白↓;转铁蛋白饱和度↓ 总铁结合力
贫血的细胞学分类
类型 MCV MCH MCHC 常见疾病
大细胞 >100 性贫血
正细胞 80性贫血 100
>34 27-34
32-35 32-35
巨幼细胞贫血、 MDS、溶血性贫 血
AA、溶血性贫血
急性失血性贫血
小细胞 <80 低色素 性贫血
<27
<32